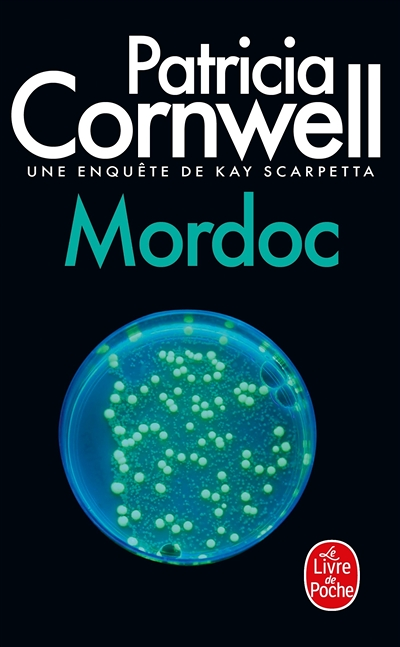
Mordoc - Une enquête de Kay Scarpetta (Poche)

8,90 €
Lame de scie à onglet 600 mm 14 dents Lame de rechange pour scie à onglet de haute qualité 600 mm avec des dents à pointe dure à double biseau pour couper le bois avec précision et efficacité.
Castorama 
8,90 €
Boîte à onglet en plastique Une boîte à onglet en plastique qui permet la coupe d'onglets à l'angle désiré
Castorama 
8,90 €
IRONSIDE
Mini scie à métaux 150 mm avec 2 lames de scie
Brico Select 
8,90 €
Oregon
3 Limes Oregon 4.5MM 11/64 Lime Oregon à poignée ergonomique profilée offrant une maîtrise de limage de la chaîne de tronçonneuse optimale
Castorama 
8,90 €
Bosch
Lame scie sauteuse T droite grossière Bosch Bois tendre T344D, lot de 2 Dotée de dents rectifiées aiguisées pour des résultats rapides
Castorama 
8,90 €
Bosch
Lame scie sauteuse T droite grossière Bosch Bois tendre T144DP, lot de 2 L'épaisseur accrue de la lame l'empêche de se plier et fournit des coupes précises.
Castorama 
8,90 €
Erbauer
Offre une coupe fine précise et souple à ras, utilisez les 2 lames de scie égoïne U droite propre Erbauer Bois Idéales pour des découpes plongeantes rapides dans bois, bois de construction 6-150 mm, planches 6-60 mm, contreplaqué, plastique 6-150 mm, panneaux de bois 175 mm. Adaptées aux bois épais, bois de chauffage, bois vert, branches et travaux de jardinage, tôles épaisses, panneaux de particules et MDF. Compatibles avec la plupart des marques de scie alternatives.
Castorama 
8,87 €
FISKARS
Pour la scie de 620 mm SW30 (article N° 1001621).
Centrale Brico 
8,84 €
SCID
Type : Fraisée, avoyéeLongueur (mm) : 150Matière : Bi-métalType d'utilisation : Aggloméré, bois avec clou, encadrement de fenêtre, métal/acier, plastique renforéNombre de pièce : 2
Cazabox
8,70 €
Des cadavres, Kay Scarpetta en a vu beaucoup dans sa carrière de médecin-légiste. Souvent démembrés, découpés, étranglés... Mais elle n'en avait pas encore vu dont la peau présente, en signe distinctif, les symptômes de la même maladie. Une maladie depuis trente ans éradiquée de la planète !Qui est donc Mordoc, tueur en série, assez audacieux pour se présenter à Kay sur l'internet, assez diabolique et assez fou pour propager un virus mortel ?Après Postmortem, Une mort sans nom et Morts en eaux troubles, la reine du thriller, au succès international, parvient à repousser un peu plus loin les limites de la terreur.Plus tranchant qu'une scie ! The New York Times.
E Leclerc 
8,70 €
SCID
Diamètre D (mm) : 20Longueur B (mm) : 2.8Longueur D (mm) : 140Nombre de dent : 20Nombre de pièce : 1Emballage Brochable : 1
Cazabox 
8,69 €
Riss
Pour le perçage des matériaux et métaux courants Profondeur de coupe 30 mm Les dents ont deux tailles différentes alternées pour optimiser la coupe Diamètre de perçage : 32 mm Hauteur : 30 mm
Cazabox 
8,65 €
FISCHER DAREX
Scie à métaux. Lame carbone, monture renforcée, poignée révolver plastique.
Brico Select 
8,62 €
GARDENA
Lame de rechange pour scie combisystem. Pour la scie horticole combisystem (réf. 691-20)
Centrale Brico 
8,50 €
Bosch
La lame étroite de ces 2 lames de scie sauteuse T droite propre Bosch Bois dur est optimisée pour la découpe en courbe sur les bois dur et matériaux de travail du bois abrasifs grâce à ses dents rectifiées précises avec corps conique rectifié permettant d'obtenir des résultats propres. Avec denture en acier haute vitesse trempé bi-métal et corps en acier carbone hautement élastique pour découper des matériaux durs.
Castorama 
8,45 €
Bosch
Débit coupe rapide Pour Bois, agglomérés, contreplaqués (50 mm max)
Cazabox 
8,39 €
Stanley
Lames scies à onglet Longueur : 560 mm
Cazabox 
8,33 €
Outibat
Longueur (mm) : 600Nombre de pièce : 1Emballage Brochable : 1
Cazabox 
8,17 €
Outibat
Longueur (mm) : 350Nombre de pièce : 1Emballage Brochable : 1
Cazabox 
8,02 €
SCID
Type : Fraisée, avoyéeLongueur (mm) : 300Matière : Chrome VanadiumType d'utilisation : Bois tendre, bois vert, bois de chauffageNombre de pièce : 2
Cazabox 
7,99 €
FISCHER DAREX
Scie égoïne FISCHER DAREX avec denture universelle. Longueur de 450 mm. Idéale pour les petits travaux de menuiserie.
Cdiscount 
7,99 €
TIVOLY
Lot de 2 lames de scie sauteuse TIVOLY pour la découpe de tous types de matériaux. - Attache en U pour Black&Decker, Skil et Ryobi. - Type de coupe : rapide.
Cdiscount 
7,99 €
TIVOLY
Scie cloche HCS multi-lames TIVOLY pour perceuse. - Diamètres des 7 lames : 25 mm, 32 mm, 38 mm, 45 mm, 50 mm, 56 mm, 62 mm. Idéal pour le perçage dans le bois dur, bois tendre, le placo et le plastique. Coupe jusqu'à 22.5 mm. - Livré avec embase et foret centreur.
Cdiscount 
7,99 €
TIVOLY
Acier de qualité découpé au laser (meilleure précision, rigidité, longévité) Lame ajourée anti-friction laser : découpe plus nette, plus précise, plus fine - Moins d'échauffementde la lame et du bois - Coupe plus rapide.
Cdiscount 
7,96 €
Stanley Fatmax
Lame de sice bi-matière Pour scie métaux Nombre de dents : 18 dents Longueur : 300 mm Vendu par 2
Cazabox 
7,95 €
Vinland Saga Thorfinn et son équipage sont en route pour la Grèce, première étape de leur expédition vers le Vinland. Ils font escale sur le continent européen, en Norvège, près de Bergen. À peine débarqué. Thorfinn est attaqué par un ours et sauvé in extremis par Hild, une chasseresse, qui leur offre de partager son repas. Alors que tous sont assis autour du feu, Hild leur raconte la nuit où sa vie a basculé, lorsqu'une horde de guerriers a saccagé son village et massacré sa famille. Au fur et à mesure de son récit, Thorfinn réalise qu'il était l'un des agresseurs et que Hild l'a reconnu...Dans l'une de mes séries de livres pour enfants préférées. Vic le Viking , il y a un mécanisme appelé scie circulaire qui permet de couper les arbres grâce à une scie animée par l'énergie d'une roue à aubes. C'est une invention de Vic, le jeune Viking. Je m'en sois très fortement inspiré pour ce tome 17. La série Vic le Viking , écrite par l'auteur suédois Runer Jonsson, a été adaptée en dessin animé au Japon, et je suis sûr que beaucoup d'entre vous la connaissent. C'est une histoire censée se passer à l'époque des Vikings. Son héros, le jeune Vic, bien qu'étant le fils unique du valeureux chef Harval, est un peu peureux. Il aime la paix et déteste les bagarres et la violence. Étant très intelligent, il résout toujours ses problèmes grâce à son ingéniosité et à ses inventions. Il découvre aussi beaucoup de nouvelles choses. Il ne faut pas garder les grandes découvertes pour soi ! dit Vic. Si on les cache, rien ne peut progresser. Si on les partage avec les autres, eux aussi nous enseigneront des choses intéressantes. Et ainsi, tout le monde vivra mieux ! Voilà un garçon qui a tout compris ! Il veut aider le plus de gens possible. Et parmi ces gens , il inclut aussi les ennemis de son père. Harval. C'est la plus grande qualité de Vic. Dans la série Vic le Viking , je ne peux pas voir le héros, les personnages, sans souhaiter que la réalité soit comme ça, j'aime qu'ils soient décrits de manière aussi simple et innocente. Ce n'est pas parce qu'on est né Viking qu'on est forcément obligé de piller et de saccager. Ce qui est juste ne coïncide pas toujours avec les traditions d'un peuple. C'est une chose que je ne veux jamais oublier. Makoto Yukimura
E Leclerc 
7,94 €
SCID
Diamètre D (mm) : 16Longueur B (mm) : 2.8Longueur D (mm) : 125Nombre de dent : 20Nombre de pièce : 1Emballage Brochable : 1
Cazabox 
7,90 €
Ribiland
Scie couteau de 30 cm avec poignée en polypropylène, un outil efficace, robuste et polyvalent.
Jardinerie Pasero 
7,90 €
SILVERLINE
en acier tubulaire ovale robuste poignée en acier à revêtement vinyle lame acier haute teneur en carbone lame de 60cm
Oogarden 
7,90 €
Bosch
Lame de scie sauteuse T droite propre Bosch Bois tendre T301CD, lot de 2 Dotée de dents rectifiées précises avec corps conique rectifié pour réaliser des coupes propres
Castorama 
7,90 €
Bosch
Lame de scie sauteuse T droite grossière dents rectifiées aiguisées Bosch Bois, lot de 2 Dotée de dents rectifiées aiguisées pour des résultats rapides
Castorama 
7,90 €
Bosch
Lame de scie sauteuse T droite propre Bosch Bois tendre T234X, lot de 2 Sa géométrie de la dent, avec une augmentation progressive de pas de denture, permet d'utiliser des matériaux avec une large gamme de densités.
Castorama 
7,90 €
Universal
Ces 3 lames de scie sauteuse T courbe propre Stratifié offrent une découpe courbe propre des matériaux stratifiés.
Castorama 
7,90 €
Universal
Ces 3 lames de scie sauteuse U droite propre Bois dur L. 100 mm permettent de réaliser une coupe propre et droite dans la plupart des bois, dur ou tendre, comme des matières plastiques, contreplaqué et panneaux de particules stratifiés.
Castorama 
7,90 €
Universal
Ces 3 lames de scie sauteuse T droite grossière Bois tendre sont parfaites pour une découpe droite grossière des bois moyens, bois tendre, OSB et contreplaqué.
Castorama 
7,90 €
Universal
Ces 3 lames de scie sauteuse U droite grossière Bois moyen sont parfaites pour une découpe droite grossière des bois moyens, durs et tendres ainsi que des OSB et contreplaqué.
Castorama 
7,90 €
Universal
Lame de scie sauteuse T droite grossière Bois moyen, lot de 3 Une lame de scie sauteuse pour une découpe droite grossière des bois moyens
Castorama 
7,90 €
Universal
Ces 3 lames de scie sauteuse T droite propre Métal fin L. 100 mm sont idéales pour une découpe droite propre des métaux fins et plus épais.
Castorama 
7,90 €
Universal
Ces 3 lames de scie sauteuse U droite grossière Bois sont idéales pour une découpe droite grossière des bois moyens, bois tendre, OSB et contreplaqué.
Castorama 
7,90 €
Universal
Ces 3 lames de scie sauteuse U droite propre inversée Bois, offrant une coupe inversée, droite et propre dans le bois, permettent de donner à la surface supérieure une finition propre sans éclats sur les bois dur et tendre, matières plastiques, OSB, contreplaqué et panneaux de particules stratifiés.
Castorama 
7,90 €
Universal
Ces 3 lames de scie sauteuse T droite propre Métal fin L. 75 mm sont idéales pour une découpe droite propre des métaux fins tels que la tôle (ferreuse ou non).
Castorama 
7,90 €
Universal
Ces 3 lames de scie sauteuse T droite grossière Bois dur offrent une coupe propre et droite dans la plupart des bois dur et tendre, OSB, contreplaqué et bois avec clous.
Castorama 
7,90 €
Universal
Lame de scie sauteuse T droite grossière Bois moyen 5/50 mm, lot de 3 Une lame de scie sauteuse pour une découpe droite grossière des bois moyens
Castorama 
7,90 €
Universal
Ces 3 lames de scie sauteuse U droite grossière (précision) Bois sont parfaites pour une découpe droite grossière des bois moyens, tendres et durs ainsi que des contreplaqués et panneaux de particules stratifiés.
Castorama 
7,90 €
Universal
Ces 3 lames de scie sauteuse T courbe propre Bois fin et moyen sont parfaites pour une découpe courbe propre des bois fins et moyens comme stratifiés double face, panneaux de particules stratifiés, MDF, bois tendre et dur et contreplaqué.
Castorama 
7,90 €
Universal
Ces 3 lames de scie sauteuse T droite grossière Bois épais sont parfaites pour une découpe droite grossière des bois plus épais, dur ou tendre.
Castorama 
7,90 €
Universal
Ces 3 lames de scie sauteuse T droite propre Bois épais sont idéales pour une découpe droite propre des bois plus épais, tendre ou dur, et également pour les contreplaqués, panneaux de particules stratifiés et matières plastiques.
Castorama 
7,90 €
Universal
Ces 3 lames de scie sauteuse T droite propre Bois dur L. 100 mm permettent de réaliser une coupe propre et droite dans la plupart des bois dur et tendre, matières plastiques, contreplaqué et panneaux de particules stratifiés.
Castorama 
7,90 €
Universal
Ces 3 lames de scie sauteuse T droite propre Alu et non-ferreux sont idéales pour réaliser des coupes droites dans les matériaux non ferreux tel que l'aluminium, les fibres de verre ou de plastique.
Castorama 
7,90 €
Universal
Ces 3 lames de scie sauteuse T droite grossière Céramique offrent un revêtement spécial pour la découpe de carrelage en céramique, carrelage mural en céramique tendre et fonte.
Castorama 
7,90 €
kwb
Jeu de 2 lames de scie sabre pour coupe-branches Einhell
Castorama 
7,88 €
Bosch
Coupe droite et fine Pour Bois et plastiques (30 mm max)
Cazabox 
7,85 €
Riss
Pour le perçage des matériaux et métaux courants Profondeur de coupe 30 mm Les dents ont deux tailles différentes alternées pour optimiser la coupe Diamètre de perçage : 30 mm Hauteur : 30 mm
Cazabox 
7,80 €
SCID
Type : Fraisée, avoyéeLongueur (mm) : 150Matière : Bi-métalType d'utilisation : Acier inox, métal/acier, feuille d'acier, tube d'acierNombre de pièce : 2
Cazabox 
7,80 €
Riss
Foret HSS Ø 6,35 mm Ø queue entrainement 6,35 mm sur plat Pour scies trépans Ø 14 à 30 mm
Cazabox 
7,75 €
Erbauer
Lame de scie égoïne U droite générale Erbauer Bois/Métal, lot de 2 Idéales pour la coupe et l'élagage de bois jusqu'à 190 mm de diamètre. Adaptées aux bois moyen à épais, bois de chauffage, bois vert, branches et travaux de jardinage, bois/métal bois avec clous/métal, tôles, tuyaux, profilés en aluminium. Compatibles avec la plupart des marques de scie alternatives.
Castorama 
7,75 €
Erbauer
Lame de scie égoïne U droite propre Erbauer tôle et profilés fins et épais ø 5-100 mm, lot de 2 Idéales pour les tôles minces et épaisses. Pour couper des tuyaux/profilés diamètre 5-100 mm. Adaptées aux Tôle mince, bois épais, bois de chauffage, bois vert, branches et travaux de jardinage, tuyaux, profilés. Compatibles avec la plupart des marques de scie alternatives.
Castorama